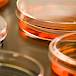
Astma - kako je liječiti?

Tražena oznaka lijekovi je pronađena na sljedećim stranicama:
-
Zanimljivosti Lažni antibiotici preplavili Europu
![Lažni antibiotici preplavili Europu]()
-
Zanimljivosti Ženska viagra uskoro u prodaji
![Ženska viagra uskoro u prodaji]()
-
Lijekovi Upozorenja na lijekovima
![Upozorenja na lijekovima]()
-
Zanimljivosti Recepti za lijekove će se uskoro pisati na internetu
![Recepti za lijekove će se uskoro pisati na internetu]()
-
Zanimljivosti Liječnici lažno potpisuju studije proizvođača
![Liječnici lažno potpisuju studije proizvođača]()
-
Zanimljivosti Rekordna prijava nuspojava lijekova
![Rekordna prijava nuspojava lijekova]()
-
Zanimljivosti Pfizer zbog prijevare plaća najveću kaznu u povijesti
![Pfizer zbog prijevare plaća najveću kaznu u povijesti]()
-
Zanimljivosti Novi antibiotici mogli bi pobijediti rezistentne bakterije
![Novi antibiotici mogli bi pobijediti rezistentne bakterije]()
-
Zanimljivosti Zbog lažnog Valiuma skinut ćete odjeću i poplavjeti
![Zbog lažnog Valiuma skinut ćete odjeću i poplavjeti]()
-
Zanimljivosti Virus izaziva bol u trbuhu, ali liječi rak
![Virus izaziva bol u trbuhu, ali liječi rak]()
-
Zanimljivosti Sporni lijekovi za hiperaktivnost kod djece koriste se i u RH
![Sporni lijekovi za hiperaktivnost kod djece koriste se i u RH]()
-
Zdravlje općenito Astma - kako je liječiti?
![Astma - kako je liječiti?]()
Najnovije zanimljivosti
Najnovije iz Zdravog života
Najnovije iz Zdravlja A-Ž
-
Recept dana
![Wok od junetine, mahuna, paprike i šampinjona]()
Wok od junetine, mahuna, paprike i...
30 min12345 -
Recept tjedna
![Juneći gulaš s krumpirom]()
Juneći gulaš s krumpirom
1 h12345 -
Recept mjeseca
![Tjestenina s brokulom]()
Tjestenina s brokulom
30 min12345